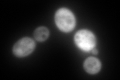
YBR115C
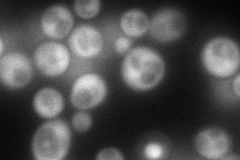
YBR115C
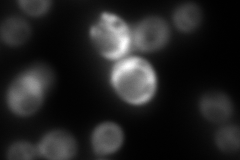
YBR115C
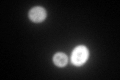
YBR115C
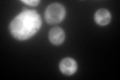
YBR115C

View description
Alpha aminoadipate reductase, catalyzes the reduction of alpha-aminoadipate to alpha-aminoadipate 6-semialdehyde, which is the fifth step in biosynthesis of lysine; activation requires posttranslational phosphopantetheinylation by Lys5p
Localization:
Intensity:
Fold change:
Significance:
-
C’ GFP library in SD
cytosol488.23 -
N' NOP1pr-GFP in SD
cytosol157.538 -
N' TEF2pr-mCherry in SD
cytosol11.194 -
N' NATIVEpr-GFP in SD

cytosol174.856 -
N' TEF2pr-VC and Cyto-VN in SD

#N/A0 -
C’ GFP library in SD+DTT
cytosol263.440.53No -
C’ GFP library in SD+H2O2
cytosol549.161.12No -
C’ GFP library in Starvation Media

cytosol275.050.56No -
C’ GFP library on the background of Pup2-DaMP

cytosol -
C’ GFP library on the background of CCT mutant

cytosol565.3641.15798No
